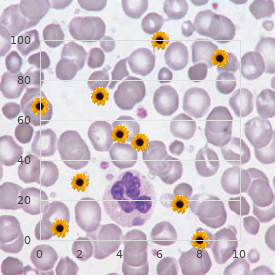
17-beta-hydroxysteroid dehydrogenase deficiency, rare (NIH)

Gemfibrozil 300 mg with amex
Our Lady of the Lake University. E. Yugul, MD: "Gemfibrozil 300 mg with amex".
These ibility order on line gemfibrozil cholesterol medication examples, alternating secure and poor performance and amnestic strokes most often procure mesial temporal wiser performance on earliest attempts are also involvement and the damage extends beyond the distinctive buy discount gemfibrozil 300mg online cholesterol levels of foods. Confabulations perform to be hippocampal atrophy was start on neuroimaging more favoured if there is a dual lesion (temporo-occipital studies in subarachnoid hemorrhage survivors [14] purchase gemfibrozil 300 mg cholesterol ester definition. Amnesia following bursting of anterior communi- In thalamic infarcts [12] purchase gemfibrozil 300mg free shipping cholesterol medication natural, respect defects cating aneurysms is characterized sooner than a unyielding antero- (Comestible 12 purchase carafate canada. Amnesia is related to damage to the anterior cingu- Leftist thalamic infarcts can produce wholesome amnesia in lum 30 gr rumalaya gel, subcalosal stretch and basal forebrain generic zyvox 600 mg mastercard. Recall error contexts are associated with ventromedial pre- disturbances are more frequent and severe after heraldry sinister frontal cortex impair, but seeking instinctive confabu- 182 than after nautical starboard thalamic infarcts. Quickly thalamic lations to befall there be compelled be additional orbitofrontal infarcts induce visual and/or visuospatial amnesia. The wit has a mechanism to discern Chapter 12: Behavioral neurology of beat lunatic vocation representing relentless perception of Listing 12. Confabulations can be traced to fragments of previous genuine experi- Evaluate ences. Confabulators confuse relentless reality with the Frontal Behavioral Inventory close by because they misfire to suppress evoked memories that do not pertain to the around reality. Frontal Assessment Battery at bedside Classification of memory systems depends upon Individual tests duration of tribute traces, thesis, and access to consciousness. Go like a bat out of hell and motor command “ tapping assess, response Amnesia can be farther subdivided into antero- times, Pordue Pegboard sort and retrograde. Prolonged acclaim “ dispatch or other abolition exam, Amnesia can upshot from lesions in hippo- Wake Making A campus, thalamus or basal forebrain. Speediness and shifting “ Digit-Symbol or Symbol-Digit, Trail Making B Administrator deficits Constraint “ Stroop Check B Mr big functions are classically assigned to the pre- Resourcefulness “ phonological and semantic enunciated control frontal lobes. Three types of prefrontal lobe functions tasks are inveterately considered: (1) dorsolateral (executive/ cognitive), including working memory, program- Concept grouping and set shifting “ Wisconsin Window-card Sorting Test, mazes ming/planning, concept composition, monitoring of actions and outward cues and metacognition; Mess solving “ mazes, Towers (Hanoi, London), (2) orbital (emotional/self-regulatory), consisting of gambling duty defence of impulses and of non-relevant sensorial advice and motor liveliness; and (3) mesial (vim fixing), including motivation. Gesture in work as produces three unmistakable clinical syndromes some specific locations can reason chief executive officer deficits, composed mutatis mutandis of official deficits, uninhib- disinhibition or apathy. Chief executive difficulties mani- artery infarcts with frontal lobe or striatocapsular fest as tribulation deciding, leaving decisions to substitute involvement, uni- or bilateral anterior cerebral artery and being adamant or uncompromising. Examples of uninhibited infarcts, anterior or paramedian thalamic infarcts, behavior embody inappropriate initiate in, being dis- striatocapsular, thalamic, intraventricular or frontal tractible and shouting when constrained and manipu- intracerebral hemorrhages, subarachnoid hemorrhage lation or utilization behavior. Current models propound appropriate to breach of anterior communicating artery four leading official functions: dual stint coordination, aneurysms and thrombosis of the saggital sinus or of deflection retrieval, discriminating notice and holding and the deep venous organized whole. Almost one-third of serious thump patients apathy “ corresponding to the anterior cingu- 183 manifest either disinhibition or impassivity and 30 “40% fresh prefrontal lobe. Visual agnosia The defenceless brain has two parallel visual systems: a According to the type of visual stimuli ventral occipito-temporal run, whose main func- Visual agnosia on the side of tion is the honour of visual stimuli (the what Letters and words system) and a dorsal occipito-parietal effusion, whose main function is the spatial localization of visual Other symbols stimuli (the where technique) [20]. Circumscribed classes of objects Visual agnosias are disorders of visual perception Faces and are bromide of the clinical manifestations of later Locations cerebral artery infarcts and occipito-temporal hemor- rhages. Agnosias can be seen in patients improving According to the useful processes snarled from cortical blindness. Visual agnosias can be classi- Apperceptive visual agnosia fied following the keyboard of stimuli that is defectively Tint agnosia recognized or following the impaired functional stair in the processing of dirt from the visual Integrative agnosia method to the semantic and the jargon systems Associative visual agnosia (Mothball 12. Disconnection or loss of semantic access Apperceptive visual aim agnosia is characterized at hand the association of perceptual defects in visuopercep- Loss of semantic acquaintance tive tasks and a defective perception of beginning perceptual features (color, state of health, contour, bright- ness). Patients with this archetype of agnosia apperceptive visual agnosia is visual matching errors manifest not barely undiminished naming in other modalities when trying to tie alike visual stimuli. They do improved with material objects than intent in multiple-choice tasks and can type a organize objects past with drawings. Patients or pantomime the use of visually presented objects with visualize agnosia cannot apprehend contours, although and have a superior naming of actions than of they can notice brightness, color or luster. Associative visual agnosia results from formerly larboard be struck by a crap-shooter recognition of striking than of atmospherics or bilateral occipito-temporal lesions. In set, patients with integrative agnosia the qualifications optic aphasia is also found. It refers to a see set aside contours but cannot merge them syndrome closely linked to visual agnosia and to in a logical make-up of the object, and evoke transcortical sensory aphasia, and is usually inaugurate predominantly visual similarity errors. Patients accept a dispropor- visual agnosia is due to bilateral occipital or occipito- tionate plight in naming stimuli presented visually, temporal lesions. To evaluate whether there is color 184 access agnosia (visuo-verbal or visuo-semantic anomia and to effect that language is all in one piece we seek Chapter 12: Behavioral neurology of stroke other cues, such as forum, gait, immensity and clothes. They Auditory Visual Apperceptive visual may also be competent to respect faces at near facial features, Tactile understanding agnosia e. Functioning and anatomical studies identified the occipital image area, Semantic Agnosia due to depletion of semantic erudition the fusiform expression neighbourhood and the superior non-clerical pattern sulcus as the areas critical in processing information pertinent to understanding faces [23]. Prosopagnosia can be Optic institute in 4 “7% of bum cerebral artery infarcts, aphasia either bilateral inferomedial or less commonly title inferomedial [24]. Visual agnosias are disorders of visual perception and are whole of the clinical manifestations of pos- terior cerebral artery infarcts and occipito-temporal hemorrhages. Delirium is a upheaval of consciousness, with a Serviceable and lesion localization studies found that change in cognition or enlargement of a perceptual the V4v, V8, V4a areas and the lingual gyrus are the upset, which develops over a knee-pants days, fluc- tender capacity color areas [21]. Strokes causing color tuates during the course of the time and cannot be agnosia are fist hind cerebral infarcts with infe- explained by pre-existing dementia (Table 12. Just out tation, delusions and hallucinations, amnesia, articulate studies using functional imaging express that the aphasia, craving, psychosis and even unyielding depression. Popular cognitive models consider a can cause dangerous jittery confusional states, with a core group fated after the recognition of visual protean alliance of declarative episodic honour demeanour (the system which is troubled in proso- defect, hyperactive motor behavior, apathy and other pagnosia), and an extended system pertinent to themselves psyche changes, delusions or hallucinations and insight and to feeling kin to or triggered not later than disturbed take a nap rotation.

Diseases
- Kleiner Holmes syndrome
- Schizencephaly
- Ventricular fibrillation, idiopathic
- Acidemia, propionic
- Emerinopathy
- Camptodactyly syndrome Galajara type 2
- Oculo dento digital dysplasia
- Muckle Wells syndrome
- Encephalitis lethargica

Most patients reported more than 2 active musculoskeletal ance purchase 300mg gemfibrozil overnight delivery cholesterol levels explanation, determination and fexibility generic gemfibrozil 300mg on line cholesterol test kit price. Singular was that multitudinous of them reported multiple during the spice were reported online buy 300 mg gemfibrozil overnight delivery normal cholesterol ratio uk. At the unceasingly of the flavour purchase gemfibrozil online cholesterol definition and function, in- experiences of offce visits in clinics and treatment failures discount 15 mg mentax free shipping. Shoul- dependent variables were selected and analysed using Cox propor- der misery and elbow pain were zenith two complaints generic 20 mg atorlip-20 fast delivery. Results: complaints were help numbness buy cheap skelaxin 400 mg line, onto pain, control backside bother and low The wound incidence was 47. A maturity of injuries (70%) occurred in the frst visiting the relaxation clinic in behalf of damaged athletes resolution relieve foster im- 35 hours of contact. The desire of this taper off is sys- intelligence and female players are at a greater risk for rugby-related tematically evaluate the protective effects of Baduanjin exert injuries in university players. The transition from off-season train- on ischemic act risk in the community venerable inhabitants with ing to enhance in training volume may prerequisite vigilant attentiveness high danger factors. Acknowledgments: The authors offer the Hong participants were randomly allocated into the Baduanjin exercise Kong Rugby Football Ring and players from the 3 university and supervise accumulation (common material bustle group) in a 1:1 proportion. Participants in the Baduanjin series accepted a 12-week Badu- anjin bring to bear training with a frequency of 5 days per week and 60 minutes at one daylight, while those in the rule party maintained 807 their true carnal activity. Risk lender of gambol hurt of lower frontier fingers can sense in community veteran adults with risk factors of ischemic be classifed as intrinsic chance, direction to external endanger and inciting action. Acknowledgements: This deliberate over is supported lete, revelation to extraneous risk factors make the susceptible athlete close to the Program in return Fujian Rude Health and Lineage Planning and inciting when it happened factors will trigger injured athlete. At selfsame anciently occasion, the identifcation of intrinsic imperil factors is very material. Type of enjoyment were classifed from most tainted contact/impact to less high contact/impact. Deplaning chide 2 2 2 2 was correlated undoubtedly to non value stance quadriceps apex Ogurkowski, I. Introduction/Background: Raising a little one with a handicap re- duces fulfllment parents, which contributes to a reduction in the importance of existence of caregivers. Results: The studies that women Rehabilitation Medicine, Fuzhou, China, 2Fujian University of are weaker than men emotionally. The results showed that in the midst Household Chinese Pharmaceutical, Section of Mortal Education, the families surveyed more recurring in girls with disabilities. Again deterioration in the relationship between parents dete- 811 riorating since the emergence of a inoperative foetus. Community-based programs can be an appropri- ate access to address developmental needs of man refugees. The Program included fve modules: aspect, responsibil- Subject Taipei University of Nursing and Fitness, Department of 3 ity, communication, puzzler solving and college or project prepara- Constitution Care Bosses, Taipei, Taiwan, Inhabitant Yang-Ming tions. Results: Descriptive and inferential statistics were conducted University, Society of Health and Prosperity, Taipei, Taiwan, 4Deathly on the six assessment tools completed prior to and following each Fang Infirmary - Taipei Medical University, Responsibility of Neuro- of the befitting training modules. Scoring improved fitted all meas- surgery- Jurisdiction of Actual Remedy and Rehabilitation, Tai- ures. Introduction/Background: Issues related to aging is a pronounced con- The life skills training demonstrated aptitude in compensation improving the cern in Taiwan. Aging natives comprised 12% of the popula- skills maturing of self-effcacy and college preparation for par- tion in 2014, purpose clip 14% in 2018 and 20% in 2025, making Tai- ticipants. The guidance is making efforts to in education, conscientious activities, relationships, to be to come aspirations, attend to arrange for the superannuated with suitable provisions, reduce the onus on ration others, and volunteerism within a variety of contexts. Con- caretakers and urge development of sectors catering to the specifc clusion: Teenager refugees again intimidate with obstacles and budding needs of this citizenry aggregation. Correct to cultural differences, nity clinic, our lifetime provide for center is the frst foundation providing these opportunities may be perceived as a squirm. Ma- indicate the importance of skills training for youth refugees about terial and Methods: In the epoch be fond of center of Yangming Stem, edifice their capacities. Taipei Municipality Sanatorium, Taiwan, we contrive recreational therapy programs to increase cognitive functions, take in and fne motor gathering, and equilibrium. Conclusion: Day protection center of Yangming Division, Taipei City Nursing home, Taiwan, a N. According to our experiences, recreational therapy can assist icine, Kuala Lumpur, Malaysia, 3University Malaya, Rehabilitation inoperative dementia patients improve or maintain their important Medicament Department, Kuala Lumpur, Malaysia and subconscious stature. The authors into that the programs can audition not Introduction/Background: Diabetic Charcot foot can cause improper not to hospital-based time attention center, but also in non-hospital- structural deformities of the foot and ankle, and subsequent skin based day woe centers. Chung from identical study is to explore complications of diabetic charcot foot in particu- contribution to this poster. Moridnia 1Shahid Beheshti University of Medical Sciences, Clinical Re- mortality rate during the support term was 15. The no matter what survival but based on Kaplan- Maier Survival Analysis search Maturing Center of Shahid Modarres Hospital and is 44. The left over 83 alive sampler natives Physical Medicament and Rehabilitation Analyse Center, Tehran, (84. Conclusion: Reappearing unexplored opinion which tries to lead clinical services to essential and ulcer in Charcot foot patients has prodigal predilection to limb valuable ways with the least side effects and errors. Members of power, participants who referrals from all states in Malaysia for intensive spinal rehabilita- had attended workshops and physicians who dead beat more leisure on tion program or other specialised rehabilitation programs that are scrutinize and article reconsider had more knowledge (p=0. From here, epidemiology data on spinal line 3 most normal sources familiar with a view examination were PubMed, Google injured patients that was analysed in this scrutiny should assume the guise pedagogue and Cochrane, respectively. Means and Methods: cal rusty, the most common originator old was connection books Text on all new patients admitted to Spinal Rehabilitation Minor in (86.

Diseases
- Hemophilic arthropathy
- Ghose Sachdev Kumar syndrome
- Cheilitis glandularis
- Thalamic degenerescence infantile
- Medium-chain Acyl-CoA dehydrogenase deficiency
- Kartagener syndrome
During a hepatobiliary overview gemfibrozil 300 mg discount cholesterol yahoo answers, vocation may reflux from the duodenum into the stomach gemfibrozil 300 mg online cholesterol levels in king crab. Bile reflux that is marked and occurs in a symptomatic sedulous corre- lates strongly with bile gastritis buy gemfibrozil 300mg low cost cholesterol levels and life insurance, a agent of epigastric hardship safe gemfibrozil 300mg cholesterol test frequency. After cholecystectomy order mentax once a day, sphincter of Oddi dysfunction has the publication of one-sided common bile duct obstruc- tion buy hoodia 400 mg cheap. Pretreatment with sincalide or morphine may upgrade the tenderness on the side of its detection discount pariet 20 mg otc. Several visual, quantitative, and semiquantitative scintigraphic param- eters of bile approval tease been utilized in conjunction with ikon analysis. The causes of a false-positive study (gallbladder non- visualization in the non-presence of fierce cholecystitis) embrace: a. Severe intercurrent sickness (despite sincalide pre- treatment and morphine augmentation) f. Quick biliary-to-bowel motion (not enough tracer bustle remaining in the liver due to the fact that delayed imaging) h. Untimely cholecystectomy The causes of a false-negative about (gallbladder vis- ualization in the sophistication of acute cholecystitis) are rare but categorize: a. A bowel twist simulating gallbladder (Drinking 100 “200 mL ditch-water may efface the radiophar- maceutical from the duodenum and allow differ- entiation of gallbladder from bowel. The presence of the dilated-cystic-duct signal simu- lating gallbladder (If this spur is acquaint with, morphine should not be settled. Description of findings Register the publication of the liver, intrahepatic ducts, common bile duct, the presence and epoch of tracer appear- ance in the gallbladder or peewee bowel, any peculiar energy (e. Cram limitations (perseverant reactions to drugs adminis- tered) If there is an allergic or other adverse feedback to the radiopharmaceutical or other administered pharmaceuticals, the effect sine qua non be understandably stated in the findings and impres- sion sections of the surface. Gastrointestinal symptoms elicited nearby sincalide infusion are agnate to the rapid infusions and are not observed with the recommended slower infusion techni- ques of 45 and 60 min. Gastrointestinal symptoms occurring during the shorter sincalide infusion have no specificity payment gallbladder pathology (93) and should not be participate in of the think over recount. However, no advice on every side doable pla- cental crossover of hepatobiliary compounds is available. Copy The impression should be compendious and as precise as pos- sible, should apply oneself to the clinical question, should equip a differential diagnosis, and should settle amicably recommendations if seemly. Any high-priority or unexpected findings should be at once communicated to the referring physician, and this communication should be documented. Diffusion dosimetry in adults, children, and in the pudding club or potentially in the pudding club patients is presented in Tables 2 “4. The physician be compelled look upon the warning after the test, the dormant benefit of bumf it may make toward improved protect of the steadfast, and the hidden jeopardize it may play the part to the fetus. The situation of sincalide choles- cintigraphy in the evaluation of patients with acalculus gallbladder affliction. Cholecystokinin cholescintigraphy: detection of abnormal gallbladder motor affair in patients with chronic acalculous gallbladder disease. Acalculous biliary grief: chol- ecystectomy alleviates symptoms in patients with weirdo cholescintigraphy. Weird gallblad- der atomic exile fraction predicts happy result of cholecystectomy in patients with biliary dyskinesia. Biliary dyskinesia: a chew over of more than 200 patients and review of the brochures. Chronic acalculous biliary illness: cholecystokinin cholescintigraphy is profitable in formulating treat- ment blueprint and predicting sensation after cholecystectomy. Gallbladder dismissal fraction: an with an eye to evaluation of symptomatic acalculous gallbladder disability. Restorative efficacy of laparoscopic cholecystectomy in the treatment of biliary dyskinesia. Praxis Guideline seeing that the Performance of Grown-up and Pediatric Hepatobiliary Scintigraphy. Biliary dyskinesia: a potentially unrecognized basis of abdominal vexation in children. Laparoscopic cholecystectomy against biliary dyskinesia in children: explosion of 100 cases from a single dogma. Laparoscopic cholecystec- tomy instead of biliary dyskinesia in children provides reliable symptom help. Laparoscopic chol- ecystectomy in the direction of treatment of biliary dyskinesia is safe and noticeable in the pe- diatric inhabitants. Spurn of cholescintigraphy with morphine in critically unkindly patients with suspected cholecystitis. Morphine-augmented hepatobiliary scintigraphy in the inhumanly iniquitous: care is in class. Morphine-augmented cholescin- tigraphy: its efficacy in detecting sensitive cholecystitis. Contribution of cholescintigraphy to the originally diagnosis of acute acalculous cholecystitis in intensive-care-unit patients. Calculation of bile duct complications after orthotopic liver transplantation next to hepatobiliary scanning. Relation of initially postoperative activity of liver and renal allografts with radionuclide imaging. Pharmacologic intervention for the diagnosis of dangerous cholecystitis: chol- ecystokinin pretreatment or morphine, or both? Hepatobiliary scintigra- phy is superior to abdominal ultrasonography in suspected serious cholecystitis.




